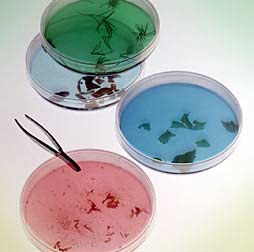
All-in-One β半乳糖苷酶分析试剂盒

相关产品推荐更多 >
万千商家帮你免费找货
0 人在求购买到急需产品
- 详细信息
- 询价记录
- 文献和实验
- 技术资料
- 库存:
大量
用途:结合M-PER蛋白抽提试剂,快速检测β半乳糖苷酶活性。
|
目录号
|
产品名称
|
规格
|
价格
RMB
|
备注
|
|||||
|
75705
|
All-in-One β半乳糖苷酶分析试剂
|
25ml
|
1083
|
||||||
|
75707
|
All-in-One β半乳糖苷酶分析试剂盒
|
Kit
25ml
25ml
25ml
|
2296
|
||||||
|
75710
|
All-in-One β半乳糖苷酶分析试剂
|
3*25ml
|
2270
|
风险提示:丁香通仅作为第三方平台,为商家信息发布提供平台空间。用户咨询产品时请注意保护个人信息及财产安全,合理判断,谨慎选购商品,商家和用户对交易行为负责。对于医疗器械类产品,请先查证核实企业经营资质和医疗器械产品注册证情况。
- 作者
- 内容
- 询问日期
文献和实验Upstate公司在世界上最先开发出步骤优化简洁的商业化ChIP分析试剂盒,保证实验的准确性和可重复性,同时Upstate提供广泛可行的ChIP级别应用抗体。ChIP基本试剂盒和特定蛋白 质ChIP级别应用抗体结合完成一个完整的染色质免疫沉淀分析。在过去的数年中,Upstate提供的ChIP分析试剂盒和ChIP级别应用抗体得到了全世界科学家的认可,文献应用极为广泛。 Upstate最新推出EZ Chip™(catalog #:17-371)分析试剂盒,较第一
一种能把乳糖水解成葡萄糖和半乳糖的酶。 EC3. 2. 1. 23。一般是指能将β -半乳糖苷水解为半乳糖和糖苷的酶。很早以来,就被认为是大肠杆菌诱导酶的典型。分子量 54万,为四聚体。其结构基因为 LacZ,与 LacY(半乳糖苷透性酶)和 LacA(半乳糖苷转乙酰酶)同组成乳糖操纵子,并在特异的乳糖操纵系统中的阻遏物、操纵基因、启动子等的协同下,支配调节β -半乳糖苷酶的合成。当培养基中无诱导物质时,每一细胞中虽然没有几个分子的β -半乳糖苷酶;但一旦被诱导,则每一
Affymetrix推出全新的OncoScan™ FFPE分析试剂盒
芯片的测试,包括黑色素瘤、神经胶质瘤、乳腺癌和脂肪肉瘤,”ARUP实验室的医学主管Sarah South评论道。“我们按照建议使用80 ng来自FFPE的DNA,并能够在48小时内完成分析。我们能够在一些关键癌基因(包括ERBB2、MDM2、EGFR和MYC)中检测到经FISH验证的畸变,表明OncoScan FFPE芯片可作为FISH检测的替代,来验证实体瘤组织中的癌基因畸变,而分辨率和特异性更高。由于OncoScan FFPE分析试剂盒有着全基因组的分辨率,我们也获得了这些样品中宝贵的拷贝
技术资料暂无技术资料 索取技术资料